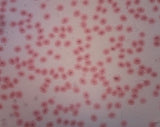

Dino-Eye Eyepiece Camera 1.3MP (USB) - AM4023CT
- USB 2.0
- C-mount Interface
- 1.3 Megapixels
The AM4023CT Dino-Eye (USB) series C-Mount digital camera sports a 1.3Megapixels sensor for digitizing observed images onto your connected LCD screen. It is specifically designed for conventional microscopes or endoscopes with a C-Mount interface or C-Mount adapter.
The intuitive software bundled with this product allows users to measure and annotate still images, and record up to 30fps of real-time clips for all microscopic applications. Its full-fledged features can complement and facilitate your task at hand, whether it is to save the produced images onto a hard drive for later inspection, or to compare various results displayed directly onto your LCD/TV screen with several people at the same time.
The AM4023CT is the ideal tool for applications that provide precise monitoring and documentation of specimen in the laboratory or on the production line.
 |
PC/MAC Compatibility |
 |
1.3 Megapixels |
 |
Professional measurement tools Use professional measurement tools that are calibratable for assured accuracy and convienently document or share information with the bundled software. |
 |
MicroTouch shutter button Take picture-perfect photos quickly and conveniently with the MicroTouch shutter button. This small, round, touch-sensitive button responds to the lightest touch to avoid blurry photos caused by excessive movement of the microscope. The MicroTouch shutter button can also be configured to control video recording, trigger barcode scanning, or switch on/off the LED lights. |
| Model | AM4023CT C-Mount camera |
| Interface | USB 2.0 |
| Product Resolution | 1.3M pixels (MJPEG codec may be required to run at 1280 x 1024 resolutions) |
| Sensor | Color CMOS |
| Frame Rate | Up to 30fps |
| Save Formats | Image: DinoCapture2.0: BMP, GIF, PNG, MNG, TIF, TGA, PCX, WBMP, JP2, JPC, JPG, PGX, RAS, PNM DinoXcope: PNG, JPEG Movie: DinoCapture2.0: WMV, FLV, SWF DinoXcope: MOV |
| Measurement Function | Yes |
| Calibration Function | Yes |
| Operating System Supported | Windows 10, 8, 7, Vista, XP MAC OS 10.4 or later |
| Unit Weight | 100g +/- 10g |
| Unit Dimension | 5cm (L) x 3.2cm (D) |
| Package Dimensions | 16cm(L) x 16cm(W) x 6cm(H) |